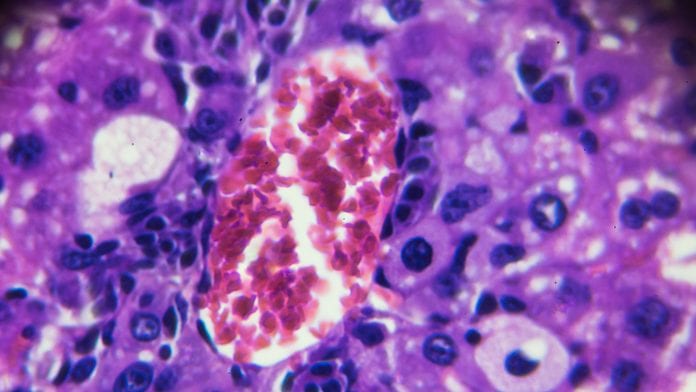

Using new tech, researchers have discovered that chronic inflammation is linked to increased risk for shorter lifespan and several organ-related diseases.
By investigating a new marker for chronic inflammation GlycA, researchers, using Nightingale Health’s blood testing technology, have found that chronic inflammation is linked with an increased risk of a wide range of diseases and shorter life expectancy.
Nightingale Health is a biotech company aiming to solve the global burden of chronic disease. The company uses proprietary blood testing technology to research into unique molecular insights that are otherwise invisible.
The hot topic that is chronic inflammation
Being linked to almost everything from heart disease to clinical depression, chronic inflammation is currently a hot topic in health and wellness. To separate fact from fiction, many researchers have been investigating the links between inflammation and different disease risks.
To investigate these connections further, scientists have used Nightingale’s blood testing technology to measure GlycA (glycoprotein acetyls), a new marker for chronic inflammation.
Glycoprotein acetyls is a powerful new way of monitoring an individual’s current state of chronic inflammation and is said to be potentially more stable than other markers used in healthcare.
What do you know about GlycA?
GlycA is a novel Nuclear Magnetic Resonance (NMR)-based biomarker for chronic inflammation. It reflects the number of N-acetyl groups in circulating glycoproteins. Typically, higher levels of GlycA correspond with an overactive immune response or persistent bacterial infection.
GlycA poses a whole host of potential clinical uses, such as informing the treatment of chronic inflammatory diseases. GlycA can also help us to identify high-risk patients, with elevated GlycA levels being previously found in large scientific studies to predict cardiovascular disease, type 2 diabetes mellitus and all-cause mortality risk.
Could GlycA be a new marker for chronic inflammation
Scientists measured GlycA from blood samples with Nightingale’s technology to explore whether the tech can predict a wide range of diseases in the general population.
Analyzing the GlycA levels of 11,861 Finnish volunteers and their electronic health records, researchers discovered that increased levels of GlycA were linked to many major internal organ related diseases i.e. alcoholic liver disease, chronic renal failure, heart failure and heart disease.
The results found that GlycA levels could successfully identify patients at five-fold risk of cardiovascular disease-related mortality.
Dr Peter Würtz, Scientific Director, Nightingale Health says: “GlycA has considerable potential as a marker of chronic inflammation that can effectively predict disease onset and prognosis.
“The findings of this paper add further evidence to support the measurement of GlycA in national biobanks, as well as its utility in future clinical applications.”









